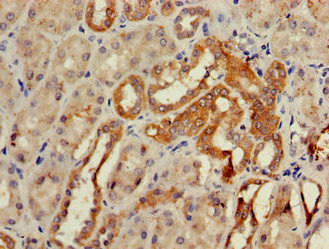

GCM2 Antibody
-
中文名稱:GCM2兔多克隆抗體
-
貨號:CSB-PA009324LA01HU
-
規格:¥440
-
圖片:
-
Western Blot
Positive WB detected in: NIH/3T3 whole cell lysate, HepG2 whole cell lysate, Rat heart tissue
All lanes: GCM2 antibody at 2µg/ml
Secondary
Goat polyclonal to rabbit IgG at 1/50000 dilution
Predicted band size: 57 kDa
Observed band size: 50 kDa -
Immunohistochemistry of paraffin-embedded human testis tissue using CSB-PA009324LA01HU at dilution of 1:100
-
Immunohistochemistry of paraffin-embedded human kidney tissue using CSB-PA009324LA01HU at dilution of 1:100
-
-
其他:
產品詳情
-
產品名稱:Rabbit anti-Homo sapiens (Human) GCM2 Polyclonal antibody
-
Uniprot No.:
-
基因名:GCM2
-
別名:GCM2 antibody; GCMB antibody; Chorion-specific transcription factor GCMb antibody; hGCMb antibody; GCM motif protein 2 antibody; Glial cells missing homolog 2 antibody
-
宿主:Rabbit
-
反應種屬:Human, Rat
-
免疫原:Recombinant Human Chorion-specific transcription factor GCMb protein (156-451AA)
-
免疫原種屬:Homo sapiens (Human)
-
標記方式:Non-conjugated
本頁面中的產品,GCM2 Antibody (CSB-PA009324LA01HU),的標記方式是Non-conjugated。對于GCM2 Antibody,我們還提供其他標記。見下表:
-
克隆類型:Polyclonal
-
抗體亞型:IgG
-
純化方式:>95%, Protein G purified
-
濃度:It differs from different batches. Please contact us to confirm it.
-
保存緩沖液:Preservative: 0.03% Proclin 300
Constituents: 50% Glycerol, 0.01M PBS, pH 7.4 -
產品提供形式:Liquid
-
應用范圍:ELISA, WB, IHC
-
推薦稀釋比:
Application Recommended Dilution WB 1:500-1:5000 IHC 1:20-1:200 -
Protocols:
-
儲存條件:Upon receipt, store at -20°C or -80°C. Avoid repeated freeze.
-
貨期:Basically, we can dispatch the products out in 1-3 working days after receiving your orders. Delivery time maybe differs from different purchasing way or location, please kindly consult your local distributors for specific delivery time.
-
用途:For Research Use Only. Not for use in diagnostic or therapeutic procedures.
相關產品
靶點詳情
-
功能:Transcription factor that binds specific sequences on gene promoters and activate their transcription. Through the regulation of gene transcription, may play a role in parathyroid gland development.
-
基因功能參考文獻:
- The present study investigated the prevalence of the Y282D variant of the GCM2 gene and its association with clinical parameters in patients with a definitive histological diagnosis of sporadic parathyroid carcinoma (SPC) or atypical adenoma (AA). PMID: 28609842
- GCM2-associated primary hyperparathyroidism patients have greater preoperative parathyroid hormone levels, a greater rate of multigland disease, a lesser rate of biochemical cure PMID: 29108698
- Our results demonstrate that germline-activating mutations affecting the C-terminal conserved inhibitory domain of GCM2 can cause familial isolated hyperparathyroidism. PMID: 27745835
- Gata3 interacted with Gcm2 and MafB, two known transcriptional regulators of parathyroid development, and synergistically stimulated the PTH promoter. PMID: 25917456
- The higher frequency of GCM2 282D in primary hyperparathyroidismand enhanced transcriptional activity of this variant supports the notion that it could contribute causally to parathyroid tumorigenesis PMID: 25279501
- we identified the genetic defect in 35% of hypoparathyroidism patients in our cohort and discovered novel GCM2 mutations including submicroscopic deletion that was undetectable by array comparative genomic hybridization PMID: 25137426
- Four single nucleotide polymorphisms of GCMB gene were found in the GCMB gene (c.-44T > C [rs16870746], c.91-242A > G [rs9379881], c.343+163G > A [rs9393726], and c.583-72A > T [rs2076257]) in our cohort. PMID: 24133354
- First described GCM2 mutation in exon 3 in patients with severe congenital hypoparathyroidism. PMID: 23155703
- Data suggest that replacement of cysteine 106 with arginine (C106R) would interfere with DNA binding of glial cells missing B (GCMB). PMID: 22066718
- We conclude that mutations in the transcription factor GCMB do not seem to play a major role in the pathogenesis of primary hyperparathyroidism. PMID: 21642377
- These results indicate that GCMB and vitamin D receptor are involved in the positive and negative regulation of parathyroid hormone gene expression, respectively. PMID: 20558332
- Gcm2 is a useful adjunct marker for the diagnosis of parathyroid lesions. PMID: 21164298
- Our results have identified the first dominant missense GCMB mutation and help to increase our understanding of the mechanism underlying gene transactivation that is a prerequisite for the function of this parathyroid gland-specific transcription factor. PMID: 20463099
- These results expand the spectrum of hypoparathyroidism-associated GCMB mutations and help elucidate the molecular mechanisms underlying DNA-binding and transactivation that are required for this parathyroid-specific transcription factor. PMID: 20190276
- significant association of R110W variant of GCM2 with isolated hypoparathyroidism PMID: 19940031
- The glial cell missing gene, GCMB , encodes a transcription factor, which is a master regulator of parathyroid development. GCMB expression is upregulated in abnormal parathyroid glands of hyperparathyroidism and decreases in response to hypocalcemia. PMID: 15657585
- Although GCM2 mutations appear to be an uncommon cause of isolated hypoparathyroidism, the wide variety of GCM2 polymorphisms suggests that variant alleles may have a role in determining parathyroid function. PMID: 18182452
- The dominant-negative effect observed in vitro for both GCMB mutations provides a plausible explanation for the impaired PTH secretion observed in the two unrelated families with autosomal dominant form of hypoparathyroidism. PMID: 18583467
- Glial cells missing-2 (GCM2) transactivates the calcium-sensing receptor gene PMID: 18712808
- one function of Gcm2 is to maintain high levels of CaR expression in parathyroid cells. PMID: 19257819
顯示更多
收起更多
-
相關疾病:Hypoparathyroidism, familial isolated (FIH); Hyperparathyroidism 4 (HRPT4)
-
亞細胞定位:Nucleus.
-
數據庫鏈接:
Most popular with customers
-
-
YWHAB Recombinant Monoclonal Antibody
Applications: ELISA, WB, IHC, IF, FC
Species Reactivity: Human, Mouse, Rat
-
Phospho-YAP1 (S127) Recombinant Monoclonal Antibody
Applications: ELISA, WB, IHC
Species Reactivity: Human
-
-
-
-
-